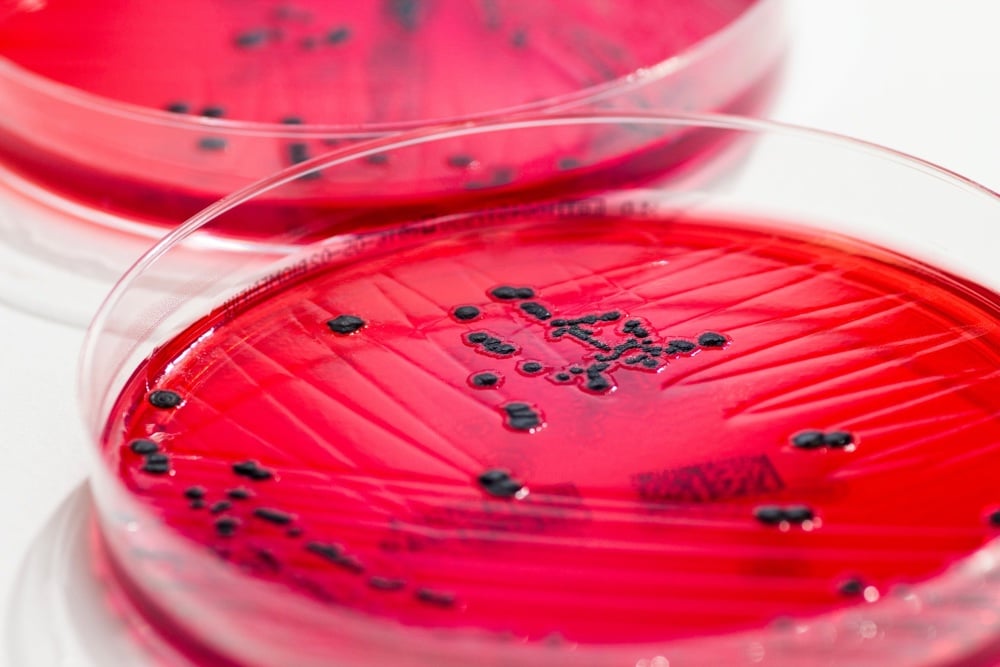

Harnessing CRISPR to fight against superbugs
Yet another potential use for CRISPR, although the gene editing technology is usually considered for macroscopic tasks, like editing mosquitoes, tomatoes, CO2-eating “ideal plants”, or even human babies, new research aims to deploy it against bacteria and viruses. An alarming number of bacteria are now resistant to one or more antibiotics, so this new line of inquiry would certainly be welcomed if it proves effective.
In their recent study, Dr. Edgell and his colleagues successfully used a Crispr-associated enzyme called Cas9 to eliminate a species of Salmonella. By programming the Cas9 to view the bacterium itself as the enemy, Dr. Edgell and his colleagues were able to force Salmonella to make lethal cuts to its own genome.
As we discover more of the benefits of our microbiota, it would also be interesting to have a solution to bacterial infections which doesn’t create problems for our “good bacteria.”
Conventional antibiotics do not distinguish between good and bad bacteria, eradicating everything indiscriminately and occasionally creating problems for people with weakened immune systems.
There’s still a long way to go though.
Now researchers face the challenge of demonstrating that Crispr antibacterial and antiviral drugs are effective in living animals and in humans, not just in the lab, and that they will be cheaper than conventional therapies, Dr. Barrangou said.




Socials & More